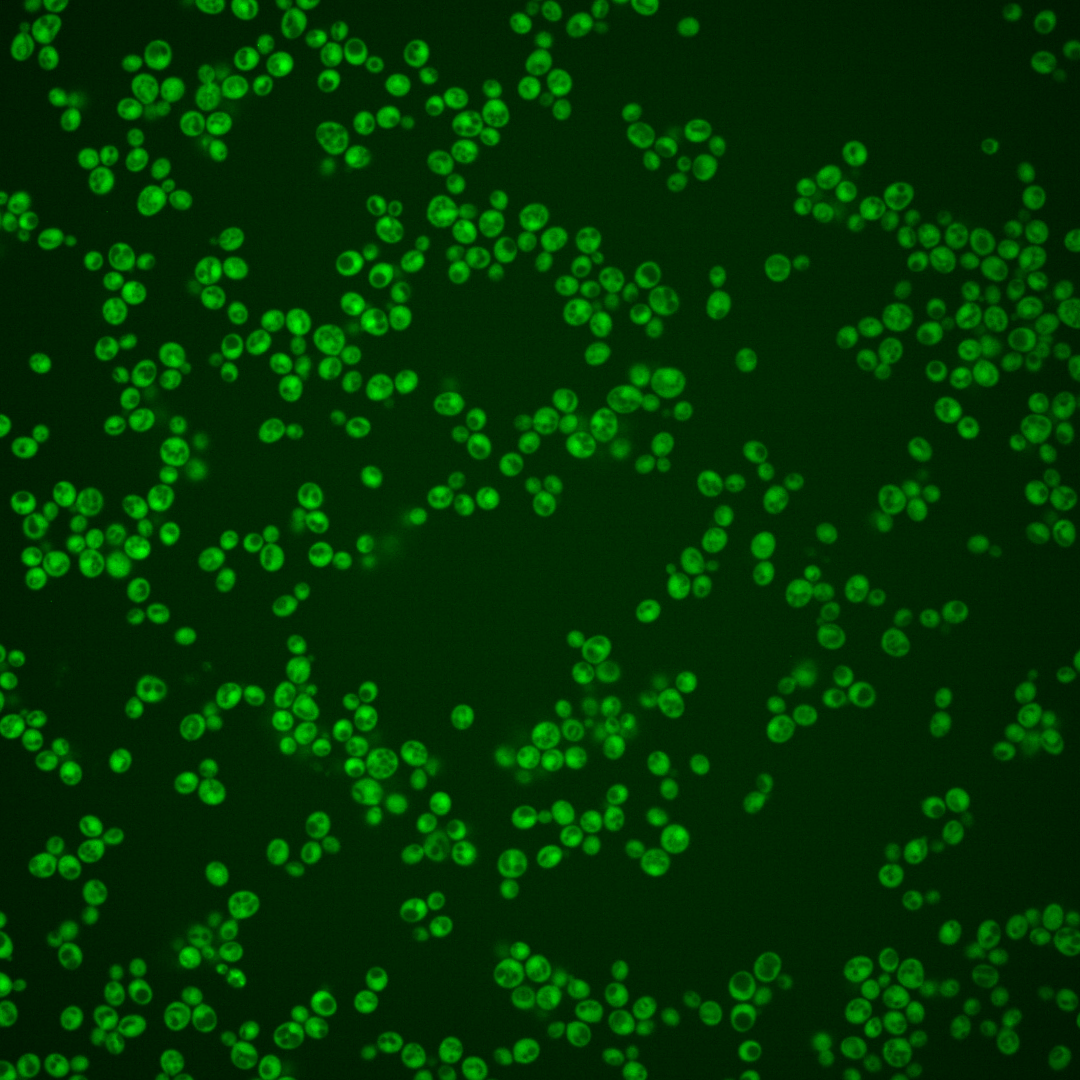
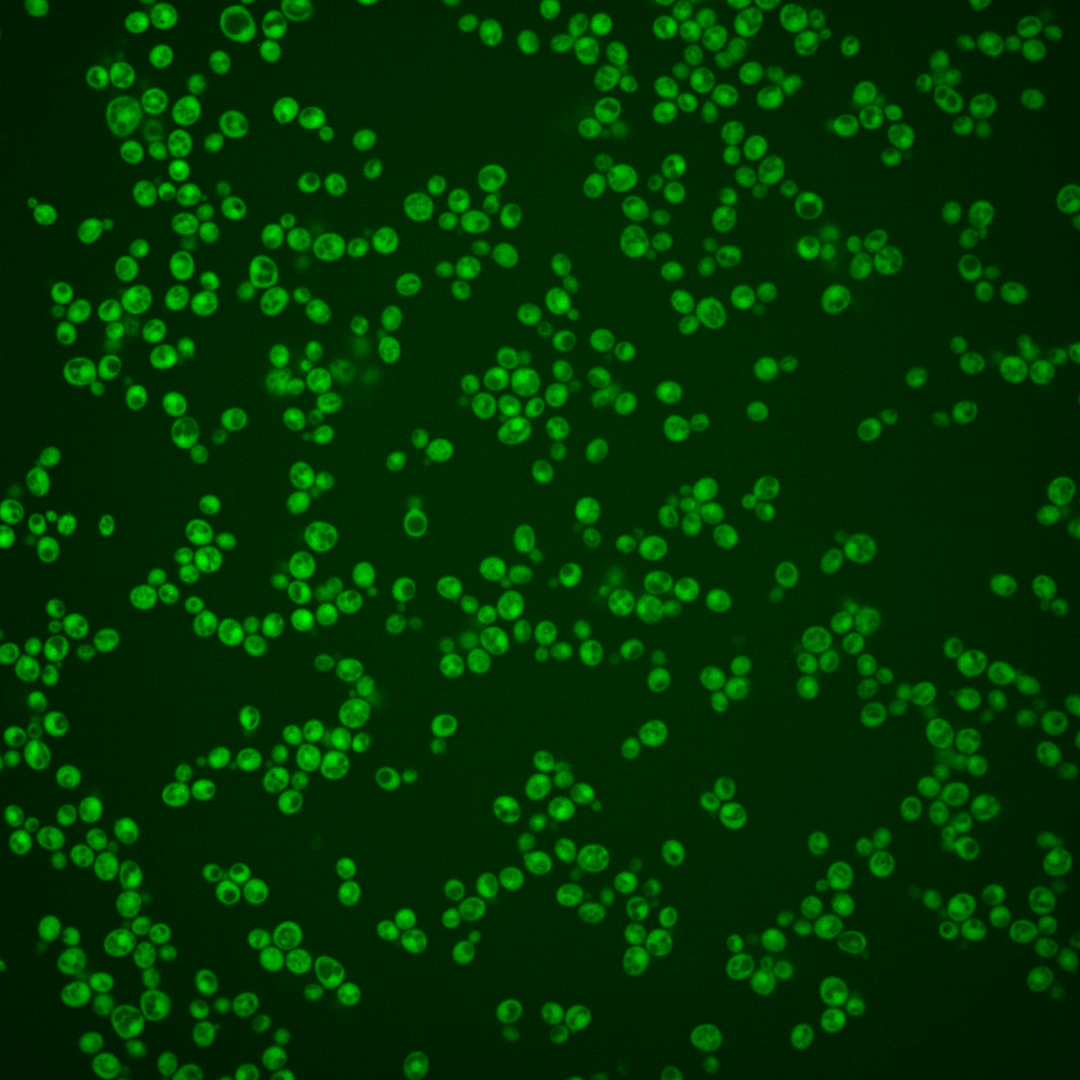
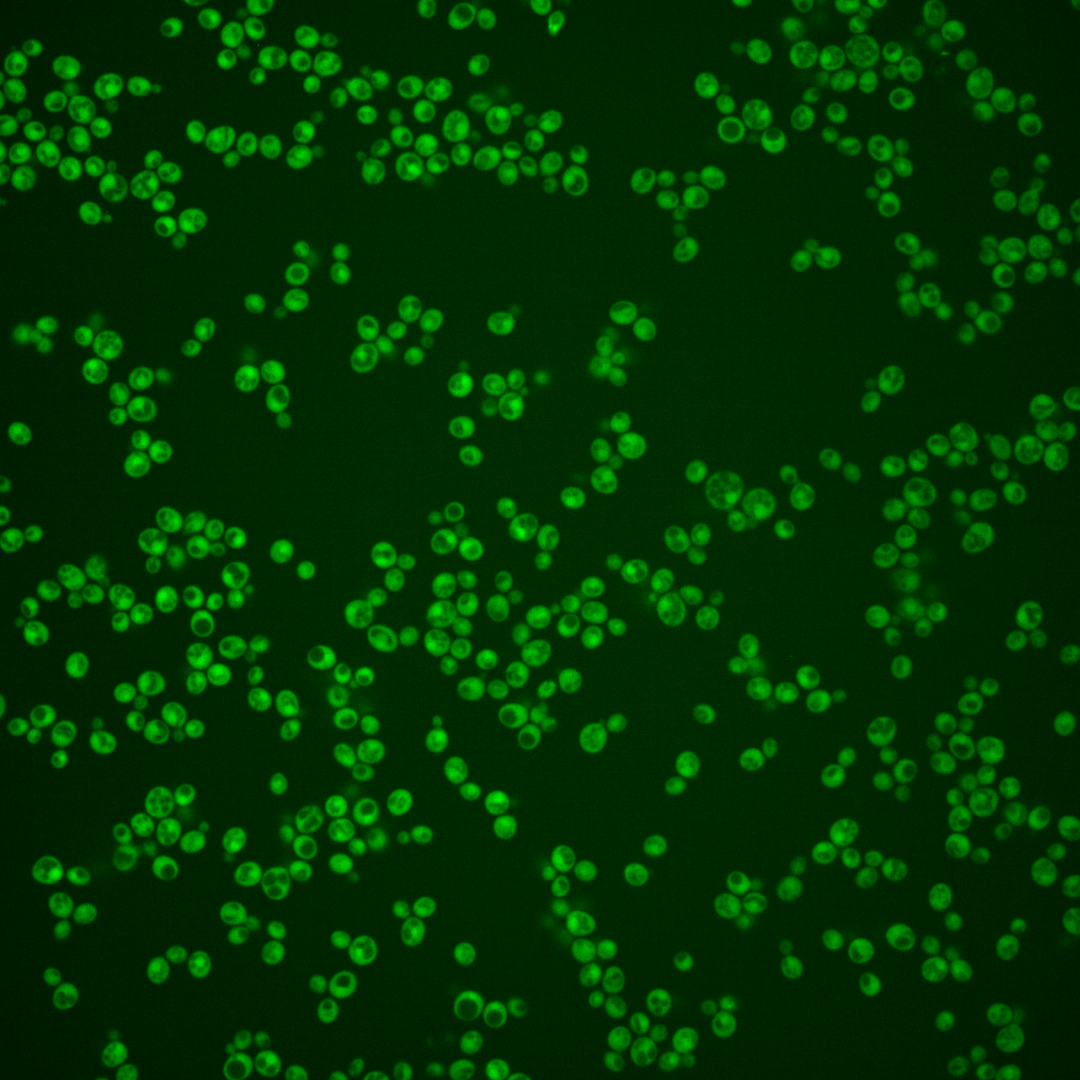
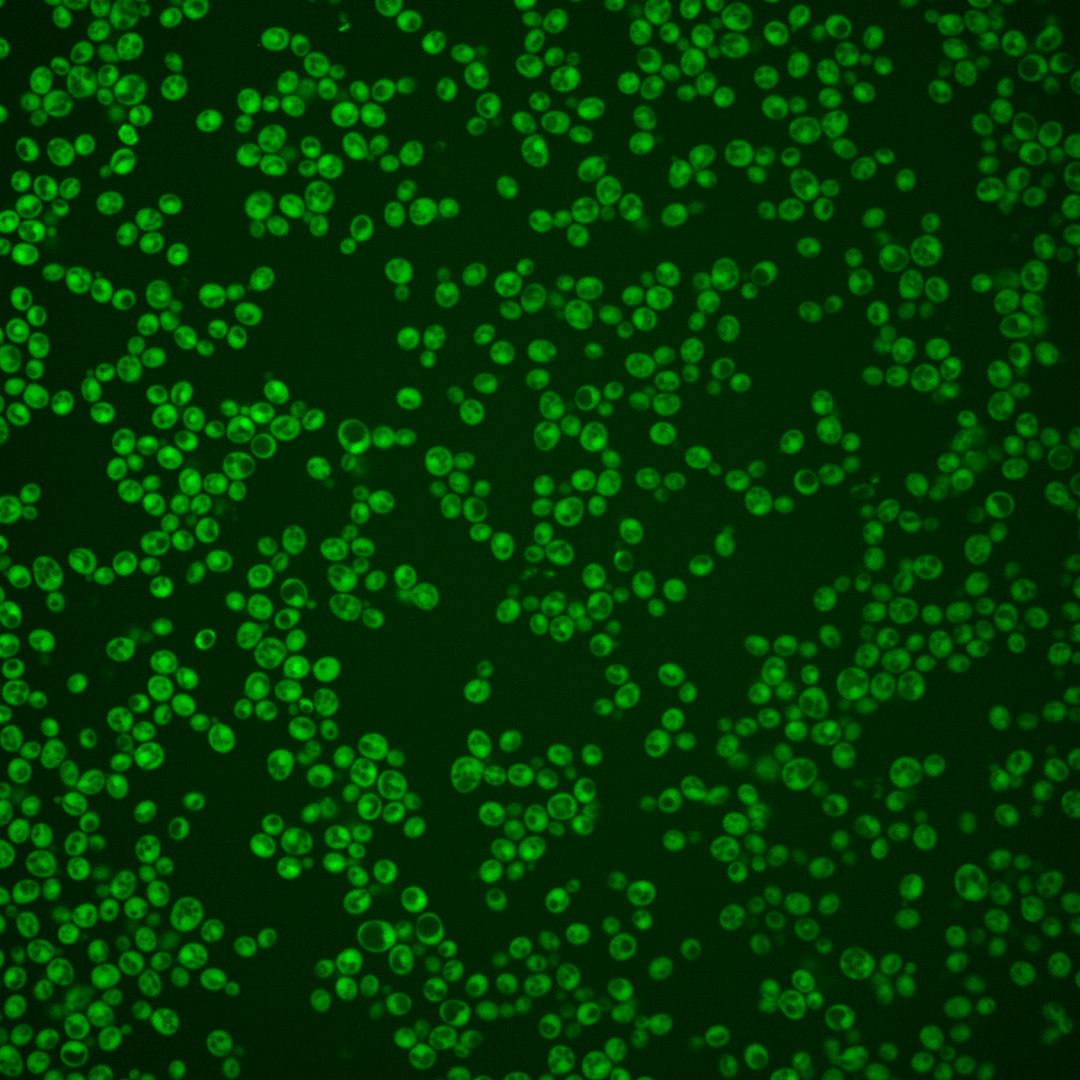
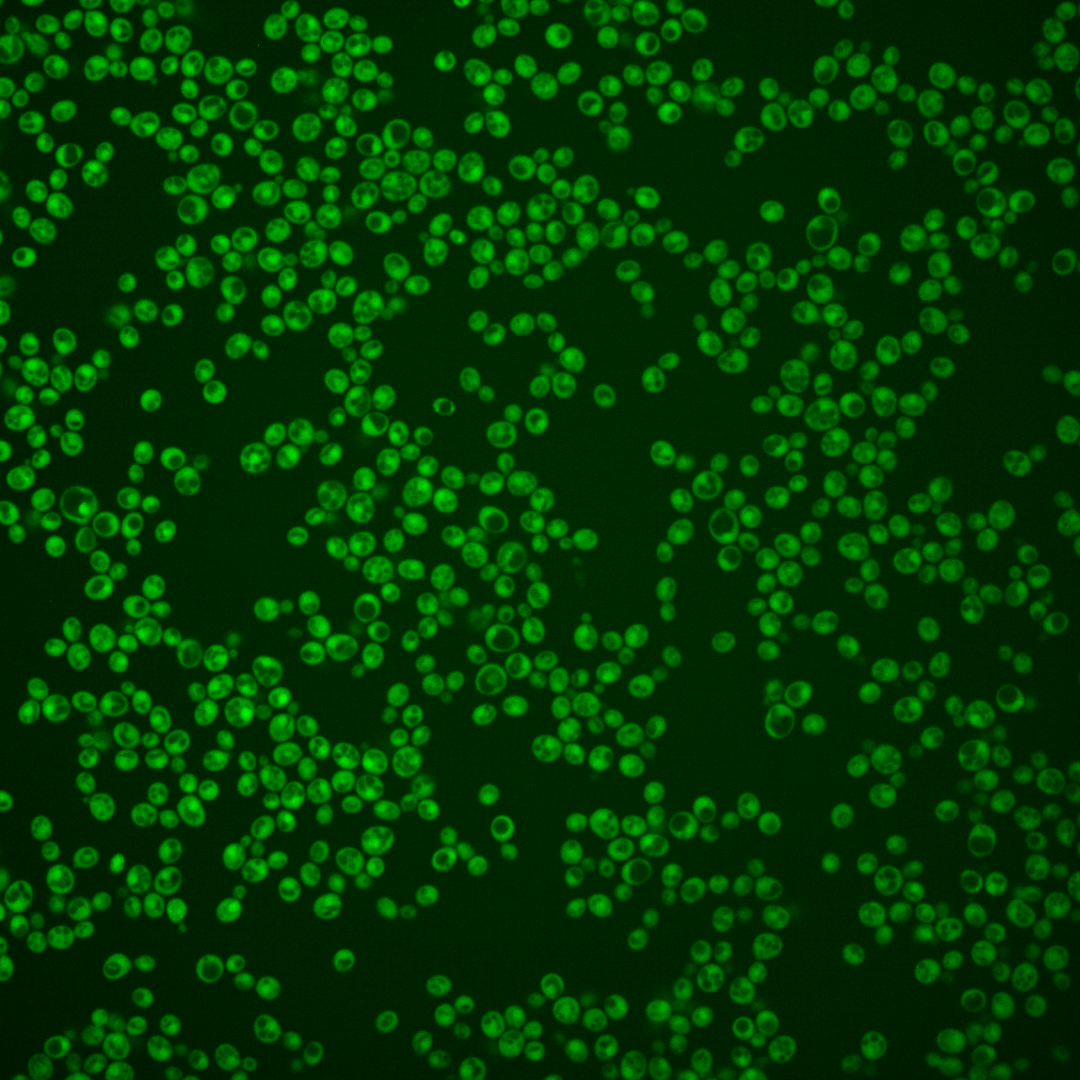
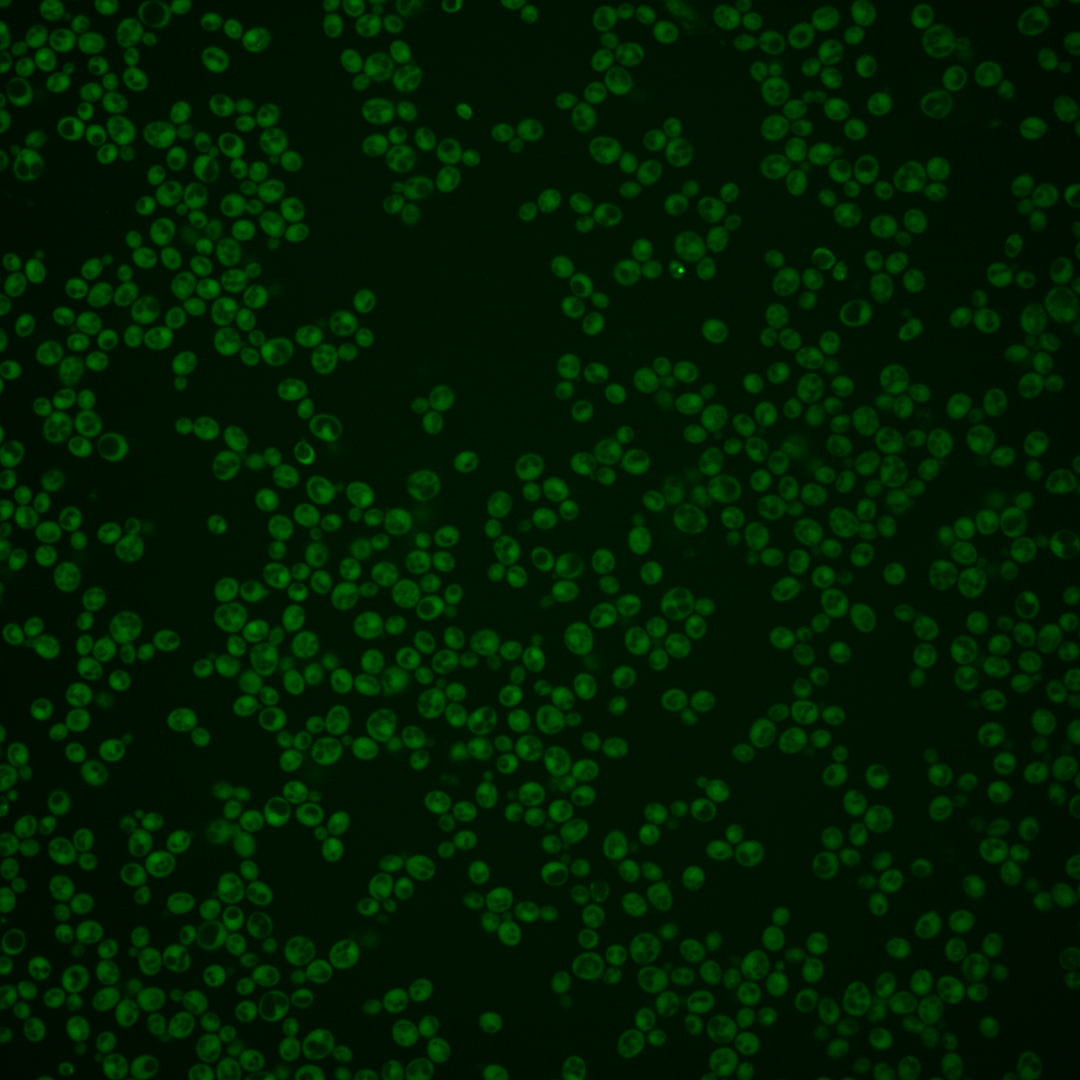

| Standard name | |
|---|---|
| Human Ortholog | |
| Description | Putative pyridoxal kinase; a key enzyme in vitamin B6 metabolism; involved in bud-site selection; diploid mutants display a random rather than a bipolar budding pattern; similarity to yeast BUD16 and human pyridoxal kinase (PDXK) |
Micrographs




















































































Sub-cellular Localization
Yeast GFP Assignment
Protein Abundance
Localization Change
External localization resources
| ensLOC | DeepLoc | |||||||||||||||||||||||
|---|---|---|---|---|---|---|---|---|---|---|---|---|---|---|---|---|---|---|---|---|---|---|---|---|
| Localization | WT1 | WT2 | WT3 | RAP60 | RAP140 | RAP220 | RAP300 | RAP380 | RAP460 | RAP540 | RAP620 | RAP700 | HU80 | HU120 | HU160 | rpd3Δ_1 | rpd3Δ_2 | rpd3Δ_3 | WT1 | WT2 | WT3 | AF100 | AF140 | AF180 |
| Cortical Patches | 0 | 0 | 0 | 0 | 0 | 0 | 0 | 0 | 0 | 0 | 0 | 0 | 0 | 0 | 0 | 1 | 0 | 0 | 0 | 0 | 0 | 0 | 0 | 0 |
| Bud | 0 | 0 | 0 | 0 | 0 | 0 | 3 | 2 | 3 | 8 | 10 | 1 | 0 | 1 | 0 | 0 | 0 | 0 | 0 | 0 | 0 | 0 | 2 | 0 |
| Bud Neck | 0 | 0 | 0 | 0 | 0 | 0 | 0 | 0 | 0 | 0 | 0 | 0 | 0 | 0 | 0 | 0 | 0 | 0 | 1 | 0 | 0 | 0 | 1 | 1 |
| Bud Site | 0 | 0 | 0 | 0 | 0 | 0 | 0 | 0 | 0 | 0 | 0 | 0 | 0 | 0 | 0 | 0 | 0 | 0 | – | – | – | – | – | – |
| Cell Periphery | 0 | 0 | 0 | 1 | 2 | 2 | 3 | 0 | 1 | 0 | 0 | 0 | 2 | 1 | 3 | 8 | 5 | 8 | 0 | 0 | 0 | 0 | 0 | 0 |
| Cytoplasm | 191 | 204 | 140 | 167 | 312 | 221 | 231 | 282 | 185 | 201 | 183 | 173 | 382 | 576 | 544 | 136 | 144 | 128 | 179 | 191 | 143 | 175 | 382 | 459 |
| Endoplasmic Reticulum | 1 | 2 | 0 | 0 | 1 | 3 | 3 | 0 | 4 | 0 | 1 | 0 | 1 | 0 | 2 | 2 | 2 | 3 | 0 | 0 | 1 | 0 | 1 | 1 |
| Endosome | 0 | 0 | 0 | 0 | 0 | 0 | 0 | 2 | 0 | 1 | 0 | 0 | 0 | 0 | 0 | 0 | 0 | 2 | 3 | 0 | 0 | 0 | 0 | 3 |
| Golgi | 0 | 0 | 0 | 0 | 0 | 0 | 0 | 0 | 0 | 0 | 0 | 0 | 0 | 0 | 0 | 1 | 1 | 1 | 1 | 1 | 0 | 0 | 0 | 0 |
| Mitochondria | 3 | 2 | 0 | 2 | 3 | 28 | 68 | 57 | 56 | 59 | 121 | 78 | 0 | 0 | 0 | 0 | 4 | 2 | 0 | 3 | 2 | 0 | 1 | 0 |
| Nucleus | 0 | 1 | 1 | 5 | 2 | 4 | 12 | 10 | 13 | 9 | 17 | 16 | 3 | 5 | 2 | 1 | 0 | 3 | 0 | 5 | 2 | 1 | 0 | 2 |
| Nuclear Periphery | 0 | 0 | 0 | 0 | 0 | 0 | 0 | 0 | 1 | 1 | 1 | 0 | 0 | 0 | 0 | 0 | 1 | 0 | 0 | 0 | 0 | 0 | 0 | 0 |
| Nucleolus | 0 | 0 | 0 | 0 | 0 | 0 | 0 | 1 | 0 | 0 | 0 | 0 | 0 | 0 | 0 | 0 | 0 | 1 | 0 | 0 | 0 | 0 | 0 | 1 |
| Peroxisomes | 0 | 0 | 0 | 0 | 0 | 0 | 0 | 0 | 0 | 0 | 0 | 0 | 0 | 0 | 0 | 0 | 0 | 0 | 0 | 0 | 0 | 0 | 0 | 0 |
| SpindlePole | 0 | 0 | 0 | 0 | 0 | 0 | 0 | 0 | 0 | 0 | 0 | 0 | 0 | 0 | 0 | 0 | 0 | 0 | 0 | 0 | 0 | 0 | 0 | 1 |
| Vac/Vac Membrane | 0 | 0 | 7 | 8 | 22 | 24 | 22 | 33 | 12 | 37 | 31 | 51 | 10 | 12 | 18 | 13 | 21 | 10 | 0 | 1 | 2 | 1 | 1 | 3 |
| Unique Cell Count | 193 | 206 | 144 | 172 | 327 | 259 | 299 | 359 | 244 | 277 | 296 | 269 | 389 | 582 | 555 | 146 | 160 | 145 | 189 | 206 | 160 | 185 | 395 | 477 |
| Labelled Cell Count | 195 | 209 | 148 | 183 | 342 | 282 | 342 | 387 | 275 | 316 | 364 | 319 | 398 | 595 | 569 | 162 | 178 | 158 | 189 | 206 | 160 | 185 | 395 | 477 |
Yeast GFP Assignment
Protein Abundance
| Screen | WT1 | WT2 | WT3 | RAP60 | RAP140 | RAP220 | RAP300 | RAP380 | RAP460 | RAP540 | RAP620 | RAP700 | HU80 | HU120 | HU160 | rpd3Δ_1 | rpd3Δ_2 | rpd3Δ_3 | AF100 | AF140 | AF180 |
|---|---|---|---|---|---|---|---|---|---|---|---|---|---|---|---|---|---|---|---|---|---|
| Mean Cell GFP Intensity (1e-4) | 6.3 | 8.7 | 7.6 | 7.3 | 7.3 | 6.1 | 5.6 | 6.1 | 5.3 | 5.8 | 5.0 | 5.4 | 7.6 | 8.0 | 8.0 | 12.1 | 11.9 | 11.9 | 7.8 | 8.5 | 8.9 |
| Std Deviation (1e-4) | 0.7 | 1.1 | 1.0 | 0.8 | 1.7 | 1.3 | 1.2 | 1.2 | 1.4 | 1.5 | 1.1 | 0.8 | 0.9 | 0.9 | 0.9 | 2.3 | 1.9 | 2.2 | 1.2 | 1.3 | 1.4 |
| Intensity Change (Log2) | – | – | – | -0.05 | -0.06 | -0.31 | -0.44 | -0.33 | -0.52 | -0.39 | -0.6 | -0.49 | 0.0 | 0.08 | 0.08 | 0.67 | 0.64 | 0.64 | 0.03 | 0.16 | 0.23 |
Localization Change
| Localization | RAP60 | RAP140 | RAP220 | RAP300 | RAP380 | RAP460 | RAP540 | RAP620 | RAP700 | HU80 | HU120 | HU160 | rpd3Δ_1 | rpd3Δ_2 | rpd3Δ_3 |
|---|---|---|---|---|---|---|---|---|---|---|---|---|---|---|---|
| Cortical Patches | 0 | 0 | 0 | 0 | 0 | 0 | 0 | 0 | 0 | 0 | 0 | 0 | 0 | 0 | 0 |
| Bud | 0 | 0 | 0 | 0 | 0 | 0 | 0 | 0 | 0 | 0 | 0 | 0 | 0 | 0 | 0 |
| Bud Neck | 0 | 0 | 0 | 0 | 0 | 0 | 0 | 0 | 0 | 0 | 0 | 0 | 0 | 0 | 0 |
| Bud Site | 0 | 0 | 0 | 0 | 0 | 0 | 0 | 0 | 0 | 0 | 0 | 0 | 0 | 0 | 0 |
| Cell Periphery | 0 | 0 | 0 | 0 | 0 | 0 | 0 | 0 | 0 | 0 | 0 | 0 | 0 | 0 | 0 |
| Cytoplasm | -0.1 | -0.9 | -3.7 | -5.3 | -5.1 | -5.5 | -6.1 | -7.9 | -7.4 | 0.7 | 1.6 | 0.6 | -1.6 | -2.5 | -2.9 |
| Endoplasmic Reticulum | 0 | 0 | 0 | 0 | 0 | 0 | 0 | 0 | 0 | 0 | 0 | 0 | 0 | 0 | 0 |
| Endosome | 0 | 0 | 0 | 0 | 0 | 0 | 0 | 0 | 0 | 0 | 0 | 0 | 0 | 0 | 0 |
| Golgi | 0 | 0 | 0 | 0 | 0 | 0 | 0 | 0 | 0 | 0 | 0 | 0 | 0 | 0 | 0 |
| Mitochondria | 0 | 0 | 4.1 | 6.2 | 5.1 | 6.2 | 6.0 | 9.0 | 7.2 | 0 | 0 | 0 | 0 | 0 | 0 |
| Nucleus | 0 | 0 | 0 | 0 | 0 | 2.4 | 0 | 2.5 | 2.6 | 0 | 0 | 0 | 0 | 0 | 0 |
| Nuclear Periphery | 0 | 0 | 0 | 0 | 0 | 0 | 0 | 0 | 0 | 0 | 0 | 0 | 0 | 0 | 0 |
| Nucleolus | 0 | 0 | 0 | 0 | 0 | 0 | 0 | 0 | 0 | 0 | 0 | 0 | 0 | 0 | 0 |
| Peroxisomes | 0 | 0 | 0 | 0 | 0 | 0 | 0 | 0 | 0 | 0 | 0 | 0 | 0 | 0 | 0 |
| SpindlePole | 0 | 0 | 0 | 0 | 0 | 0 | 0 | 0 | 0 | 0 | 0 | 0 | 0 | 0 | 0 |
| Vacuole | -0.1 | 0.8 | 1.6 | 1.0 | 1.6 | 0 | 2.7 | 2.0 | 3.9 | 0 | 0 | -0.9 | 1.4 | 2.5 | 0.7 |
External localization resources
Images






























Protein Concentration and Protein Localization Data
| R1 | R2 | R3 | ||||||||||||||||
|---|---|---|---|---|---|---|---|---|---|---|---|---|---|---|---|---|---|---|
| G1 Pre-START | G1 Post-START | S/G2 | Metaphase | Anaphase | Telophase | G1 Pre-START | G1 Post-START | S/G2 | Metaphase | Anaphase | Telophase | G1 Pre-START | G1 Post-START | S/G2 | Metaphase | Anaphase | Telophase | |
| Concentration | 1.2027 | 1.9543 | 1.7884 | 1.4478 | 1.1279 | 1.6921 | 2.2925 | 2.9235 | 2.5722 | 1.6498 | 2.7579 | 2.4716 | 2.1076 | 2.7938 | 2.4006 | 2.5615 | 2.4073 | 2.1161 |
| Actin | 0.014 | 0.0011 | 0.0104 | 0.0138 | 0.0015 | 0.008 | 0.023 | 0.0012 | 0.0139 | 0.0012 | 0.0523 | 0.0084 | 0.0319 | 0.0009 | 0.0335 | 0.0364 | 0.0437 | 0.0044 |
| Bud | 0.0006 | 0.0004 | 0.0004 | 0.0005 | 0.0026 | 0.0006 | 0.002 | 0.0037 | 0.0031 | 0.0001 | 0.0036 | 0.0006 | 0.0044 | 0.0005 | 0.0044 | 0.0063 | 0.0348 | 0.0054 |
| Bud Neck | 0.002 | 0.0004 | 0.0009 | 0.0007 | 0.0007 | 0.0024 | 0.0097 | 0.0004 | 0.0012 | 0.0005 | 0.0017 | 0.0149 | 0.0017 | 0.0004 | 0.005 | 0.0014 | 0.0012 | 0.0013 |
| Bud Periphery | 0.0006 | 0.0002 | 0.0011 | 0.0003 | 0.0012 | 0.0006 | 0.0019 | 0.0011 | 0.0022 | 0 | 0.0043 | 0.0004 | 0.005 | 0.0004 | 0.0015 | 0.0038 | 0.0114 | 0.0021 |
| Bud Site | 0.0028 | 0.0017 | 0.0007 | 0.0008 | 0.0056 | 0.0006 | 0.0085 | 0.0057 | 0.0086 | 0.0003 | 0.0047 | 0.0003 | 0.0041 | 0.004 | 0.0083 | 0.0119 | 0.0041 | 0.0003 |
| Cell Periphery | 0.0001 | 0 | 0.0001 | 0 | 0.0001 | 0 | 0.0004 | 0.0001 | 0.0002 | 0.0001 | 0.0002 | 0 | 0.0012 | 0.0002 | 0.0005 | 0.0005 | 0.0005 | 0.0002 |
| Cytoplasm | 0.6262 | 0.7955 | 0.7519 | 0.7192 | 0.667 | 0.781 | 0.6033 | 0.8385 | 0.8172 | 0.8446 | 0.544 | 0.8122 | 0.7362 | 0.8117 | 0.7424 | 0.6733 | 0.6887 | 0.8193 |
| Cytoplasmic Foci | 0.0292 | 0.0101 | 0.0122 | 0.0144 | 0.0122 | 0.0253 | 0.0546 | 0.005 | 0.0115 | 0.0064 | 0.0413 | 0.0167 | 0.0223 | 0.003 | 0.0151 | 0.0469 | 0.0142 | 0.0204 |
| Eisosomes | 0.0002 | 0 | 0.0001 | 0 | 0 | 0.0001 | 0.0002 | 0 | 0.0001 | 0 | 0.0004 | 0 | 0.0002 | 0 | 0.0002 | 0.0002 | 0.0002 | 0.0001 |
| Endoplasmic Reticulum | 0.0046 | 0.0027 | 0.0031 | 0.0028 | 0.0028 | 0.0038 | 0.0067 | 0.0024 | 0.0025 | 0.0047 | 0.0055 | 0.0034 | 0.0084 | 0.0048 | 0.0092 | 0.0071 | 0.0164 | 0.0036 |
| Endosome | 0.0217 | 0.0058 | 0.0058 | 0.0052 | 0.005 | 0.0137 | 0.0381 | 0.0012 | 0.0024 | 0.0032 | 0.0354 | 0.0099 | 0.0134 | 0.0011 | 0.014 | 0.0192 | 0.0157 | 0.0113 |
| Golgi | 0.0051 | 0.0003 | 0.0013 | 0.0012 | 0.0003 | 0.0014 | 0.009 | 0.0002 | 0.0007 | 0.0003 | 0.0188 | 0.0015 | 0.0015 | 0.0001 | 0.0057 | 0.0094 | 0.0068 | 0.0022 |
| Lipid Particles | 0.0083 | 0.0001 | 0.001 | 0.0003 | 0.0002 | 0.001 | 0.0108 | 0.0001 | 0.0005 | 0.0003 | 0.0467 | 0.0011 | 0.0008 | 0.0001 | 0.0012 | 0.0055 | 0.0041 | 0.001 |
| Mitochondria | 0.0079 | 0.0005 | 0.0028 | 0.0011 | 0.0005 | 0.0017 | 0.0092 | 0.0003 | 0.0008 | 0.0003 | 0.0053 | 0.0006 | 0.0021 | 0.0002 | 0.0037 | 0.0062 | 0.0037 | 0.0035 |
| None | 0.2286 | 0.1415 | 0.168 | 0.1898 | 0.235 | 0.1095 | 0.1577 | 0.1195 | 0.1106 | 0.1176 | 0.1207 | 0.0889 | 0.1261 | 0.1652 | 0.1219 | 0.0976 | 0.0756 | 0.1023 |
| Nuclear Periphery | 0.0058 | 0.0035 | 0.0041 | 0.0035 | 0.0037 | 0.0049 | 0.0121 | 0.0013 | 0.0024 | 0.0023 | 0.0167 | 0.0035 | 0.0176 | 0.0016 | 0.0074 | 0.0137 | 0.0102 | 0.004 |
| Nucleolus | 0.0004 | 0.0002 | 0.0004 | 0.0003 | 0.0009 | 0.0004 | 0.0014 | 0.0002 | 0.0005 | 0.0001 | 0.0019 | 0.0002 | 0.0013 | 0.0001 | 0.0005 | 0.0009 | 0.0021 | 0.0009 |
| Nucleus | 0.0121 | 0.0294 | 0.0228 | 0.0234 | 0.0453 | 0.0257 | 0.0079 | 0.0137 | 0.0119 | 0.015 | 0.0066 | 0.0225 | 0.0113 | 0.0037 | 0.0099 | 0.0142 | 0.0258 | 0.012 |
| Peroxisomes | 0.0215 | 0.0004 | 0.0035 | 0.0162 | 0.0006 | 0.0034 | 0.0226 | 0.0003 | 0.0018 | 0.0002 | 0.0219 | 0.001 | 0.0005 | 0.0001 | 0.0013 | 0.0105 | 0.0014 | 0.0003 |
| Punctate Nuclear | 0.0058 | 0.0041 | 0.0066 | 0.0032 | 0.0133 | 0.0142 | 0.0134 | 0.0042 | 0.007 | 0.002 | 0.0653 | 0.0127 | 0.0054 | 0.0011 | 0.012 | 0.0297 | 0.0356 | 0.003 |
| Vacuole | 0.0019 | 0.0017 | 0.0019 | 0.0029 | 0.0014 | 0.0014 | 0.0046 | 0.0009 | 0.0008 | 0.0007 | 0.0015 | 0.0008 | 0.0024 | 0.0008 | 0.0019 | 0.0038 | 0.0025 | 0.0016 |
| Vacuole Periphery | 0.0006 | 0.0003 | 0.0008 | 0.0004 | 0.0003 | 0.0004 | 0.0031 | 0.0001 | 0.0002 | 0.0001 | 0.0012 | 0.0002 | 0.0022 | 0.0001 | 0.0006 | 0.0014 | 0.0011 | 0.0009 |
Sequencing Data
| R1 | R2 | |||||||||
|---|---|---|---|---|---|---|---|---|---|---|
| G1 Post-START | S/G2 | Metaphase | Anaphase | Telophase | G1 Post-START | S/G2 | Metaphase | Anaphase | Telophase | |
| Gene Expression | 27.1803 | 11.3733 | 19.1807 | 21.1459 | 21.7441 | 21.9634 | 16.4653 | 22.2259 | 21.5461 | 21.8908 |
| Translational Efficiency | 0.6352 | 1.041 | 0.6154 | 0.4937 | 0.64 | 0.9084 | 0.968 | 0.5566 | 0.578 | 0.6826 |
Hit Data
| Dataset | Hit |
|---|---|
| Protein Concentration | ✘ |
| Protein Localization | ✘ |
| Gene Expression | ✘ |
| Translational Efficiency | ✘ |
Endocytosis
| Temp | Actin Patch (Sac6-tdTomato) | Cortical Patch (Sla1-GFP) | Late Endosome (Snf7-GFP) | Vacuole (Vph1-GFP) |
|---|---|---|---|---|
| 37℃ | ||||
| RT |
Cell Cycle Omics
CYCLoPs (Bud17-GFP)
| Gene / Allele | Actin Patch (Sac6-tdTomato) | Cortical Patch (Sla1-GFP) | Late Endosome (Snf7-GFP) | Vacuole (Sac6-tdTomato) |
|---|
| Gene | Images |
|---|
| Gene | Images |
|---|
Images are not yet available
Images are not yet available